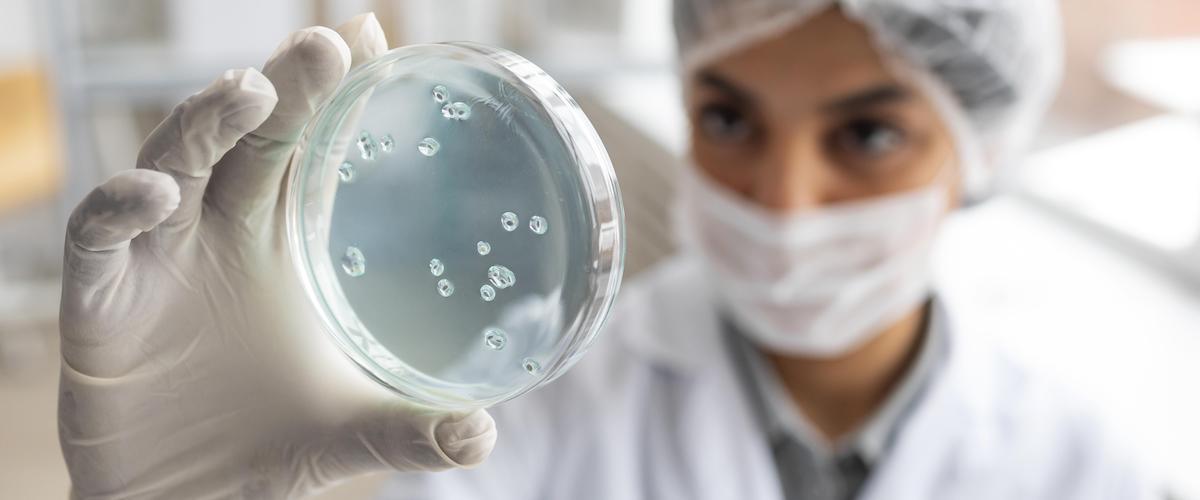
Valutazione del Rischio Legionella

Quando un utente accede al sito Web, servizi, app, i nostri fornitori di servizi autorizzati possono usare cookie, web beacon e altre tecnologie similari per scopi pubblicitari e per memorizzare le informazioni, al fine di offrirti un'esperienza migliore, più veloce e più sicura.
Attraverso questa informativa intendiamo fornirti alcune indicazioni sulle tecnologie adottate e su come vengono usate nei nostri siti e nei nostri servizi, app e strumenti. Di seguito vengono riepilogati alcuni aspetti importanti da conoscere riguardo all'utilizzo di tali tecnologie.
Cosa sono i cookie, i web beacon e tecnologie similari
Usiamo file di dati di piccole dimensioni, che vengono salvati sul tuo computer, tablet, telefono cellulare o altro dispositivo mobile (indicati complessivamente come "dispositivo") per registrare determinati dati ogni volta che accedi o interagisci con i nostri siti, servizi, app, sistemi di messaggistica e strumenti.
I nomi e i tipi specifici di cookie, web beacon e altre tecnologie similari usati possono cambiare nel tempo. Per aiutarti a comprendere meglio le regole e l'uso di tali tecnologie, di seguito sono riportati alcuni termini con le relative definizioni:
Cookie: piccoli file di testo (formati in genere da lettere e numeri) che vengono salvati nella memoria del browser o del dispositivo quando visiti un sito o visualizzi un messaggio. I cookie consentono a un sito di riconoscere un particolare dispositivo o browser. Esistono diversi tipi di cookie:
• temporanei (o di sessione): sono utilizzati per archiviare informazioni temporanee, consentono di collegare le tue azioni durante quella sessione specifica e sono rimossi dal computer alla chiusura del browser utilizzato;
• permanenti (o salvati): sono utilizzati per archiviare informazioni, ad esempio il nome e la password di accesso, in modo da evitare che l'utente debba ridigitarli ogni volta che visita un sito specifico; rimangono memorizzati nel computer anche dopo aver chiuso Internet Explorer;
• di prima parte: derivano dal sito Web visualizzato e possono essere permanenti o temporanei; possono essere utilizzati per archiviare informazioni che verranno riutilizzate alla successiva visita del sito;
• di terze parti: derivano da annunci di altri siti, ad esempio popup o striscioni pubblicitari, presenti nel sito Web visualizzato; possono essere utilizzati per registrare l'utilizzo del sito Web a scopo di marketing.
I cookie possono essere disattivati o rimossi usando gli strumenti disponibili nella maggior parte dei browser. Le preferenze relative ai cookie devono essere impostate separatamente per ciascun browser usato, poichè ognuno di essi offre funzionalità e opzioni specifiche. L'Utente può trovare informazioni su come gestire i Cookie con alcuni dei browser più diffusi ai seguenti indirizzi: Google Chrome, Mozilla Firefox, Apple Safari e Microsoft Internet Explorer.
Web beacon: frammenti di codice che consentono a un sito web di trasferire o raccogliere informazioni attraverso la richiesta di un'immagine grafica; possono essere utilizzati per diversi fini, quali l'analisi dell'uso dei siti web, attività di controllo e reportistica sulle pubblicità e la personalizzazione di pubblicità e contenuti;
Tecnologie similari: tecnologie che archiviano dati nel browser o dispositivo usando oggetti condivisi a livello locale o archiviazione locale, quali cookie flash, cookie HTML 5 e altri metodi software per applicazioni web. Queste tecnologie funzionano in tutti i browser. In alcuni casi l'uso dell'archiviazione locale non può essere pienamente gestito dai browser, ma richiede la gestione tramite strumenti specifici.
I cookie dei nostri siti
I nostri cookie hanno diverse funzioni. Sono utili per assicurare il funzionamento dei nostri servizi, ci permettono di migliorare le prestazioni. Usiamo cookie e tecnologie similari che rimangono sul tuo dispositivo solo per il periodo di attività del browser (cookie di sessione) o per un periodo più lungo (cookie persistenti).
Puoi bloccarli, eliminarli o disattivarli se il tuo dispositivo lo consente. Puoi gestire i cookie e le preferenze dei cookie nelle impostazioni del dispositivo o del browser.
Laddove possibile, vengono implementate misure di sicurezza per impedire l'accesso non autorizzato a cookie e tecnologie simili. Un codice univoco garantisce che solo noi e/o i nostri fornitori di servizi autorizzati possano accedere ai dati dei cookie.
I fornitori di servizi sono aziende che ci supportano in vari aspetti della nostra attività, occupandosi, ad esempio, di operazioni, servizi, app, pubblicità e strumenti del sito. Usiamo i nostri fornitori di servizi autorizzati per presentarti pubblicità in linea con i tuoi interessi sui nostri servizi e in altre pagine Internet. Tali fornitori di servizi possono inserire cookie nel tuo dispositivo tramite i nostri servizi (cookie di soggetti terzi). Possono anche acquisire
informazioni che consentono loro di identificare il tuo dispositivo, quale l'indirizzo IP o altri codici univoci o di dispositivo.
Determinate funzioni, servizi, app e strumenti del sito sono disponibili solo attraverso l'uso di queste tecnologie. Potrai sempre bloccarle, eliminarle o disattivarle se il tuo browser, l'app installata o il dispositivo usato lo consentono.
Alcuni dei servizi elencati di seguito raccolgono statistiche in forma aggregata ed anonima e potrebbero non richiedere il consenso dell'Utente o potrebbero essere gestiti direttamente dal Titolare. Per informazioni dettagliate in merito, si consiglia di consultare le privacy policy dei servizi elencati.
Interazione con social network e piattaforme esterne
Questo tipo di servizi (esempio: pulsante mi piace e widget social) consentono di interagire con i social network, o con altre piattaforme esterne, direttamente dalle pagine di questo sito. Le informazioni acquisite sono soggette alle impostazioni privacy dell’Utente relative ad ogni social network.
Remarketing e behavioral targeting
Questo tipo di servizi consente a questo sito ed ai suoi partner di comunicare, ottimizzare e servire annunci pubblicitari basati sull'utilizzo passato di questa Applicazione da parte dell'Utente, tramite il tracciamento dei Dati di Utilizzo e l'uso di Cookie, informazioni che vengono trasferite ai partner a cui l'attività di remarketing e behavioral targeting è collegata.
Facebook Remarketing (Facebook, Inc.)
Facebook Remarketing è un servizio di Remarketing e Behavioral Targeting fornito da Facebook, Inc. che collega l'attività di questa Applicazione con il network di advertising Facebook. Questo tipo di servizi consente a questo sito ed ai suoi partner di comunicare, ottimizzare e servire annunci pubblicitari basati sull'utilizzo passato di questa Applicazione da parte dell'Utente, tramite il tracciamento dei Dati di Utilizzo e l'uso di Cookie, informazioni che vengono trasferite ai partner a cui l'attività di remarketing e behavioral targeting è collegata.
Privacy Policy
–
Opt Out
Facebook Custom Audience (Facebook, Inc.)
Facebook Custom Audience è un servizio di Remarketing e Behavioral Targeting fornito da Facebook, Inc. che collega l'attività all’interno di questo sito con il network di advertising Facebook.
Privacy Policy
–
Opt Out
Monitoraggio conversioni di Facebook Ads (Facebook, Inc.)
è un servizio che effettua statistiche collegando i dati provenienti dal network di annunci Facebook con le azioni compiute all'interno di questo sito.
Privacy Policy
–
Opt Out
Google Analytics (Google Inc.)
Google Analytics è un servizio di analisi di cookie e dati personali raccolti allo scopo di tracciare ed esaminare l’utilizzo di questo sito, stilare report e personalizzare gli annunci del proprio network pubblicitario.
Privacy Policy
–
Opt Out
Fini statistici
I servizi contenuti nella presente sezione permettono al Titolare del Trattamento di monitorare e analizzare i dati di traffico e servono a tener traccia del comportamento dell’Utente.
Consenso all'utilizzo dei cookie
Al primo accesso alla nostro sito Web, chi naviga trova un banner contenente l'informativa breve sull'utilizzo dei cookie e può:
cliccare sul tasto "OK" (posizionato in basso a destra), che equivale al consenso all'utilizzo dei cookie, così come indicato nell'informativa breve;
• Accedere alla Cookie Policy, conoscere le diverse tipologie di cookie, le finalità di utilizzo, leggere le privacy policy dei nostri fornitori ed, eventualmente, effettuare opt-out;
• Continuare a navigare nel sito, accettando implicitamente l'utilizzo di tutti i cookie.
• Per ulteriori informazioni sui cookie di soggetti terzi relativi alla pubblicità e su come disattivarli, puoi visitare i seguenti siti web:
Allaboutcookies.org
Youronlinechoices.com
Pagina del Componente Aggiuntivo Google
Webchoices Browser Check
Network Advertising Initiative
Per ogni ulteriore informazione sul trattamento dati del sito di Hideea puoi consultare la Privacy Policy completa o scrivere a: dpo@hideea.com”
Dati Titolare trattamento dati
Titolare del Trattamento dei Dati: Hideea Srl
P.IVA: 11100241006
Legale Rappresentante: Giorgio Scrocca
Indirizzo: Via Giuseppe Rosaccio 6, 00156 Roma
Telefono: 0664502209
Email: dpo@hideea.com
Pec: hideea@legalmail.com
Sito istituzionale: hideea.com
Data Protection Officer
Nome e cognome: Antonello Dionisi
Data e luogo di nascita: Roma, 03/02/1978
Indirizzo: Via delle Rondini 86, 00169 Roma
Telefono: 3495576835
Email: dpo@hideea.com
Pec: hideea@legalmail.com